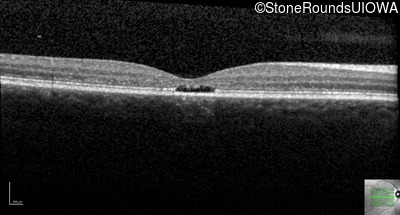
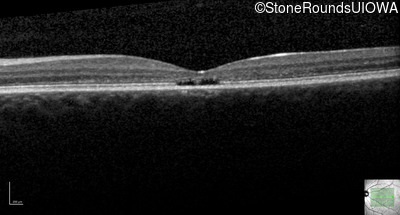
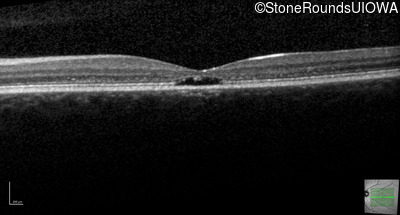
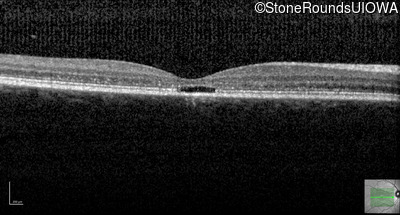
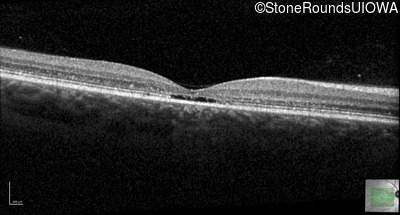
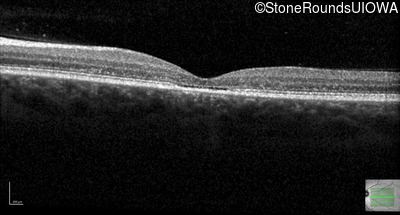

Case
SR2161
Student Mode
AR Stargardt Disease (IIA)
Female
Female
Hidden
SR2161
Student Mode
AR Stargardt Disease (IIA)
Female
Female
History
This 17 year old female first noted problems with her visual acuity around age 13 when she had trouble seeing the projector from the back of the classroom.
| Age at visit: 16 years |
| Age at visit: 17 years |
| Age at visit: 18 years |
| OD | OS | ||
|---|---|---|---|
| OD | OS | ||
|---|---|---|---|
| OD | OS | ||
|---|---|---|---|
Diagnosis & molecular findings
| Disease | Gene | Allele 1 variant(s) | Allele 2 variant(s) | Inheritance mode |
|---|---|---|---|---|
| AR Stargardt Disease | ABCA4 | Val256Val GTG>GTT | Gly1961Glu GGA>GAA | AR |
Disease:
Gene:
Allele 1:
Val256Val GTG>GTT
Allele 2:
Gly1961Glu GGA>GAA
Inheritance:
AR